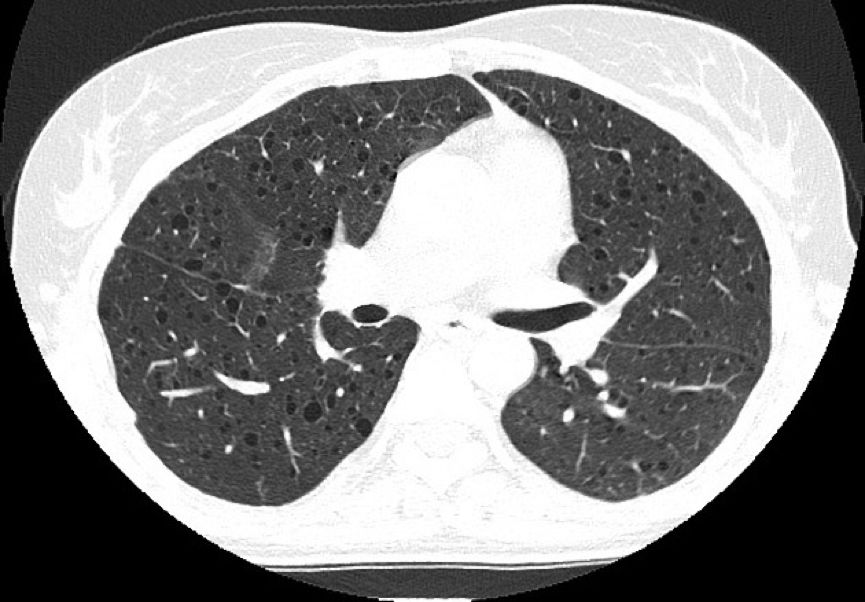
双肺上叶胸膜下见薄壁空腔正常吗,双肺多发类圆形薄壁透亮影严重吗

不想错过界哥的推送?
戳上方蓝字“医学界 呼吸 频道”关注我们
并点击右上角“···”菜单,选择“设为星标”

肺淋巴管平滑肌瘤病是什么?
文|水如烟
来源|医学界影像诊断与介入频道
病例介绍
患者,女性,39岁,反复咳嗽、咳痰3年,气促1年。体格检查示右肺语颤减弱,呼吸音明显降低。实验室检查无明显异常。血气分析:PaO2、PaCO2均降低。
外院肺功能检查提示:阻塞性通气功能障碍。HRCT显示双肺弥漫性分布类圆形薄壁囊状阴影,囊壁较光滑,囊腔大小不等,多数在2~10 mm之间,右侧胸腔内见气体影。纵隔结构清楚,未见肿大淋巴结。
诊断:肺淋巴管平滑肌瘤病(PLAM)



01
PLAM是什么?
PLAM是一种病因不明、持续发展的弥漫性肺间质疾病。表现为不典型增生的平滑肌细胞侵袭肺组织,包括气道、血管和淋巴管。主要发生在育龄期妇女,约50%合并肾血管平滑肌脂肪瘤,约2.5%结节性硬化患者同时合并PLAM病,常被误诊。
02
PLAM有何临床表现?
进行性呼吸困难为主要症状,临床常见症状为活动后呼吸困难、咳嗽、胸痛、咯血、反复发作的自发性气胸及乳糜胸等。
03
PLAM有何 影像学表现?
X线表现
病变早期在胸片可无明显异常表现,晚期出现两肺弥漫分布的网状影、粟粒状影、网状结节影或囊状影及肺气肿改变,常伴有胸腔积液及胸膜肥厚,但这些表现均缺乏特异性。
CT表现
常规CT表现为两肺密度减低,体积增大,呈肺气肿样改变。HRCT对本病的早期诊断及病情发展的监测有重要意义,其特征性改变为两肺广泛弥漫性分布的薄壁小囊状病变,两侧对称,无上中下肺野的区别,也无中央性与周围性的分布差异。囊腔直径为2~30 mm,大多数直径小于10 mm,囊壁厚度多小于2 mm。
再看两个类似病例
病例1:患者女性,45岁,呼吸短促,有反复气胸的病史。

病例2:患者女性,36岁,胸痛一周加重伴呼吸困难。

04
如何进行鉴别诊断?
1.肺气肿:在HRCT呈多发小圆形低密度区,呈分叶状,部分融合,囊壁有或无。分布不均,囊状低密度区中央可见小叶中央动脉,无小叶间隔增厚。而PLAM囊状影有明确均匀薄壁,分布均匀,血管影位于囊状影边缘。此外,结合年龄、性别、病史等因素可鉴别。
2.组织细胞增生症:与PLAM相似,在HRCT上呈囊状影,但其形态、大小不规则,囊壁厚薄不均,常见多发结节、空洞结节伴存,而且在分布上以中上肺为主,肺底和肋膈角区相对正常,另外无乳糜胸水。
3.肺间质纤维化:肺间质纤维化末期可呈广泛蜂窝状影,但囊状影呈厚壁,形状不规则,囊状影间纤维化明显。病变分布不均匀,以两下肺胸膜下分布为主。
小结
中年女性反复发生气胸及出现原因不明的呼吸困难、咯血或乳糜胸时,应疑诊是否有PLAM,当HRCT示双肺散在、多发薄壁囊腔时,一定要想到PLAM的可能性。
参考资料:
1.赵杰. 肺淋巴管肌瘤病病例报告及文献复习[D].遵义医学院,2018.
2.胡丽娟,李扬彬.CT诊断肺淋巴管平滑肌瘤病1例[J].中国CT和MRI杂志,2008,(2):77-78.
3.https://radiopaedia.org/articles/lymphangioleiomyomatosis-1